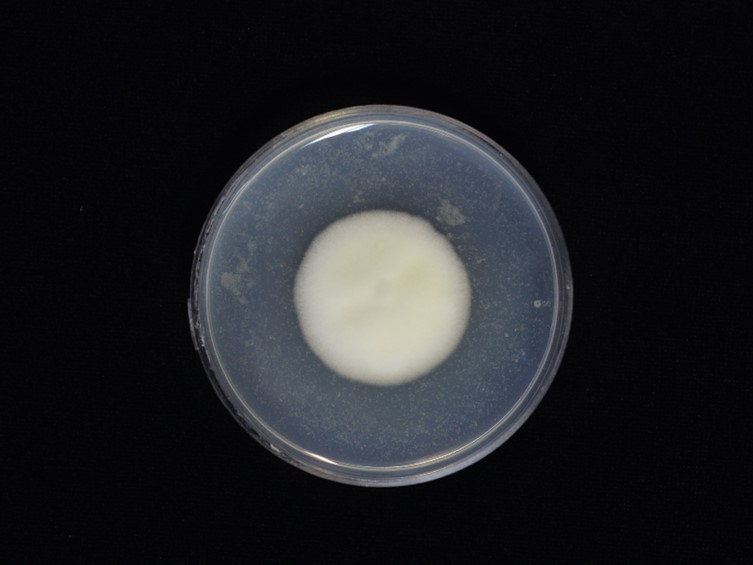

Holotype:
THAILAND, Chiang Mai Province, Kanlayaniwatthana District, Ban Huai Baba community forest nature trail, 25 Nov. 2015, D. Thanakitpipattana, K. Tasanathai, P. Srikitikulchai, R. Promharn, S. Mongkolsamrit, S. Wongkanoun & W. Noisripoom, holotype BBH40778, ex-type living culture BCC79887.
Habitat:
Stem of living plants and underside of dicotyledonous leaves
Host:
Adult moth
Description:
 Specimens found on adult moths (Lepidoptera) on the stem of living plants and
underside of dicotyledonous leaves, thin whitish mycelium covering the host body.
Specimens found on adult moths (Lepidoptera) on the stem of living plants and
underside of dicotyledonous leaves, thin whitish mycelium covering the host body.  Perithecia superficial, scattered on the host body, ovoid, strong orange, 400−530 × 180−200
µm.
Perithecia superficial, scattered on the host body, ovoid, strong orange, 400−530 × 180−200
µm.  Asci cylindrical, hyaline, 273−568 × 4−5 µm. Asci-caps umbonate, hyaline, 2.5−3.5 × 4−5 µm. Ascospores filiform, multi-septate, breaking into part-spores, hyaline. Part-spores
cylindrical, hyaline, 5–22 × 0.5−1 µm.
Asci cylindrical, hyaline, 273−568 × 4−5 µm. Asci-caps umbonate, hyaline, 2.5−3.5 × 4−5 µm. Ascospores filiform, multi-septate, breaking into part-spores, hyaline. Part-spores
cylindrical, hyaline, 5–22 × 0.5−1 µm.
Culture characteristics:
Colony on PDA closely appressed to the agar surface, compact, velvet, entire margin, attaining a diam of 29–32 mm in 20 d, white, occasionally pale greenish yellow (2D) in the middle.
Conidia and reproductive structures are not observed on both media after
30 d of incubation at 25 °C.
Colony on PDA closely appressed to the agar surface, compact, velvet, entire margin, attaining a diam of 29–32 mm in 20 d, white, occasionally pale greenish yellow (2D) in the middle.
Conidia and reproductive structures are not observed on both media after
30 d of incubation at 25 °C.
Reference:
A. Khonsanit, D. Thanakitpipattana, S. Mongkolsamrit, et al. (2024). A phylogenetic assessment of Akanthomyces sensu lato in Cordycipitaceae (Hypocreales, Sordariomycetes): introduction of new genera, and the resurrection of Lecanicillium. Fungal Systematics and Evolution14:271–305.
DOI: https://doi.org/10.3114/fuse.2024.14.17Species |
Strain |
Compound |
Pubchem CID |
Biological activity |
Reference |
|---|
|
Strain |
- |
|---|---|
| BCC 40747 | - |
| BCC 79887T | - |